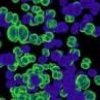
Бактерии используют наночастицы, созданные человеком

Новости - Страница 50
Ребенок прооперирован в утробе матери на сроке 26 недель
2012-03-16 22:58:00
Информационные системы в здравоохранении: взгляд со стороны
2012-03-16 22:55:32
Выводы Министра Здравоохранения
2012-03-16 22:45:32
Бактерии используют наночастицы, созданные человеком
2012-03-15 18:45:32
Инвестиции помогут создать инновационное лекарство против вирусных гепатитов B и D
2012-03-15 15:45:32
Смерть после обезболивания
2012-03-15 13:45:32
Робот-хирург на компьютеной платформе Linux
2012-03-14 19:45:32
Синтезирована сетчатка глаза
2012-03-14 11:45:32
Министр сельского хозяйства кардиолог, Министр Здравоохранения экономист
2012-03-14 10:45:32
Магнитная буря возвращается
2012-03-13 22:45:32